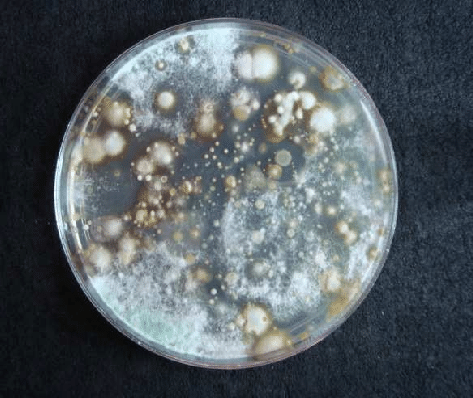

Carlos MERENSON Los microbiólogos conocen detalladamente los procesos de crecimiento de los microorganismos. Ellos no se sorprenden cuando en minutos o algunas horas ven pasar ante sus ojos todas las etapas de crecimiento de una población de bacterias. Ellos preparan en una caja de Petri un medio rico en nutrientes y siembran una cepa. Observan … Continuar leyendo EL PLANETA PETRI
0 Comentarios